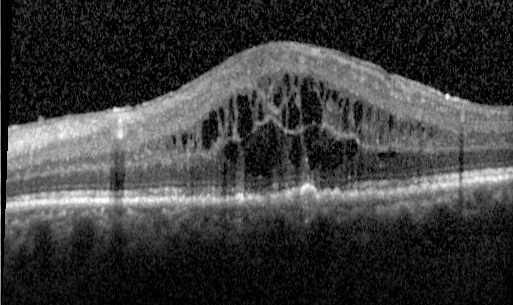

Un patient de 30 ans se présente à votre consultation. Il est diabétique de type 1 depuis l'âge de 10 ans. Il ne prend aucun autre traitement que l'insuline qu'il dit «gérer», bien qu'il ne fasse pas de contrôle glycémique quotidien. Sa dernière hémoglobine glyquée est de 11,3 %.
Le patient vous rapporte également qu'il fume un paquet de cigarettes par jour depuis 8 ans.
Dans ses antécédents familiaux, vous retrouvez de l'hypertension artérielle chez ses deux parents.
Á l'examen, l'acuité visuelle de loin corrigée est de 4/10e à droite avec -2 (-0,50 à 180°) et de 10/10e à gauche avec -1,75 (-0,50 à 10°) ; l'acuité visuelle de près est de Parinaud 5 à droite et Parinaud 2 à gauche sans correction.
La pression intraoculaire est à 16 mmHg aux deux yeux. L'examen à la lampe à fente retrouve des deux côtés un œil blanc et indolore, une cornée claire, un test à la fluorescéine négatif, une chambre antérieure calme, une absence de rubéose irienne, une absence d'opacités cristalliniennes.
L'examen retrouve également un tuméfaction de la paupière supérieure droite, peu douloureuse, ne gênant pas la vision, sans communication avec le follicule pileux et apparue 10 jours auparavant. Il vous dit également qu'il avait eu ce genre de «boule» l'année dernière sur la paupière inférieure droite et qu'elle avait régressé en quelques jours avec une pommade corticoïde dont il ne se souvient plus le nom.
Le fond d'œil retrouve à droite, un œdème maculaire, des hémorragies rétiniennes dans les quatre quadrants, des néovaisseaux prérétiniens, une absence d'hémorragie intravitréenne, une absence de décollement de rétine et à gauche des micro-anévrismes disséminés, un néovaisseau prérétinien, une absence d'hémorragie intravitréenne, une absence de décollement de rétine. Le rapport cup /disc est de 0,3 aux deux yeux.
Le patient vous rapporte également qu'il fume un paquet de cigarettes par jour depuis 8 ans.
Dans ses antécédents familiaux, vous retrouvez de l'hypertension artérielle chez ses deux parents.
Á l'examen, l'acuité visuelle de loin corrigée est de 4/10e à droite avec -2 (-0,50 à 180°) et de 10/10e à gauche avec -1,75 (-0,50 à 10°) ; l'acuité visuelle de près est de Parinaud 5 à droite et Parinaud 2 à gauche sans correction.
La pression intraoculaire est à 16 mmHg aux deux yeux. L'examen à la lampe à fente retrouve des deux côtés un œil blanc et indolore, une cornée claire, un test à la fluorescéine négatif, une chambre antérieure calme, une absence de rubéose irienne, une absence d'opacités cristalliniennes.
L'examen retrouve également un tuméfaction de la paupière supérieure droite, peu douloureuse, ne gênant pas la vision, sans communication avec le follicule pileux et apparue 10 jours auparavant. Il vous dit également qu'il avait eu ce genre de «boule» l'année dernière sur la paupière inférieure droite et qu'elle avait régressé en quelques jours avec une pommade corticoïde dont il ne se souvient plus le nom.
Le fond d'œil retrouve à droite, un œdème maculaire, des hémorragies rétiniennes dans les quatre quadrants, des néovaisseaux prérétiniens, une absence d'hémorragie intravitréenne, une absence de décollement de rétine et à gauche des micro-anévrismes disséminés, un néovaisseau prérétinien, une absence d'hémorragie intravitréenne, une absence de décollement de rétine. Le rapport cup /disc est de 0,3 aux deux yeux.
Question 1 : Concernant la réfraction du patient :
La presbytie apparaît plus tard vers 45 ans. Le patient est P2 à gauche sans correction.
La myopie forte est supérieure à 6 dioptries.
Le patient est myope et astigmate aux deux yeux.
Le patient est astigmate de -0,50 dioptries à 180° à l'œil droit.
-2 à droite versus -1,75 à gauche.
L'hypermétropie correspond à un œil pas assez convergent ou trop petit par rapport à sa convergence. L'image d'un objet se forme donc en arrière de la rétine. La correction de l'hypermétropie se fait par des verres sphériques convexes, ou des lentilles de contact, ou par chirurgie réfractive.
L'astigmatisme correspond à une perte de la sphéricité de la cornée. La correction de l'astigmatisme se fait par des verres cylindriques convexes ou concaves, ou des lentilles de contact, ou par chirurgie réfractive.